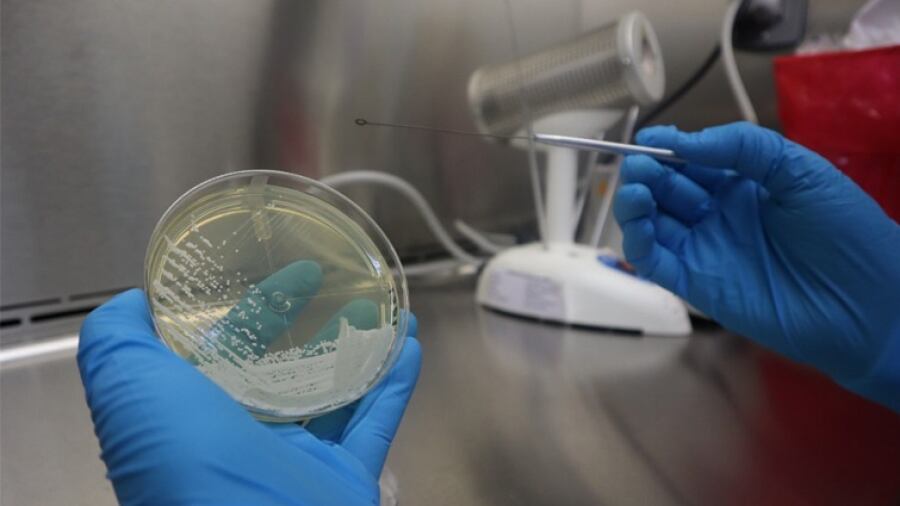

Desde que se descubrió el primer caso en Guatemala, en diciembre de 2020, el hongo Candida auris mantiene en alerta al Laboratorio Nacional.
El Candida auris, es una especie de hongo que crece como levadura, y ha sido identificado recientemente, explicó César Conde, jefe del Laboratorio Nacional de Salud, durante una entrevista en el programa A Primera Hora de Emisoras Unidas. El experto indicó que Cándida es el nombre del hongo que incluso está dentro del cuerpo, en el tracto gastrointestinal y en las mucosas del cuerpo. Por lo general, nuestro sistema inmune mantiene los hongos bajo control. Sin embargo, la comunidad científica ha determinado que el Candida auris, es resistente a la mayoría de los medicamentos para tratar las infecciones por hongos.
“Es de reciente descubrimiento. Desde 2016 se ha reportado que causa enfermedades severas, sobre todo en pacientes hospitalizados y que están inmunosuprimidos, es decir que tienen problemas con sus sistema inmune”, detalló Conde.
Dos casos confirmados en Guatemala El Ministerio de Salud emitió una alerta dirigida a laboratorios, hospitales públicos y privados y áreas de salud por el primer hallazgo de Candida Auris en Guatemala. Pero hasta ahora son dos los casos confirmados, aclaró Conde. “Eso de hecho ya aparece reportado en la actualización que hace la Organización Panamericana de la Salud (OPS), en la región de aislamiento de Candida auris en el contexto de la pandemia de Covid-19″, indicó Conde. El Ministerio de Salud y Asistencia Social (MSPAS) emitió una alerta e informó que el primer paciente con Candida Auris es un hombre de 32 años, sin registro de viaje, que fue ingresado al Hospital Roosevelt por una infección en la pierna derecha. Hospital San Juan de Dios. Foto: Johan ORDONEZ / AFP. “A partir de la muestra analizada, se tuvo el aislamiento de un hongo el cuál fue confirmado como Candida Auris en el Laboratorio del Hospital San Juan de Dios, y posteriormente comunicado por Laboratorio Nacional de Salud”, describe la alerta emitida.
“Es importante mencionar que esta especie ataca principalmente a pacientes con sistema inmunológico debilitado pudiendo causar como mayor complicación candidemia, una infección severa en la sangre. En pacientes con su sistema inmunológico estable solo causa colonización”, añade el texto.
Datos importantes
El jefe del Laboratorio Nacional explicó las principales particularidades de la variante Candida auris:
¿Cómo se detecta? Es un microorganismo difícil de identificar y las técnicas convencionales usadas en los laboratorios no lo pueden detectar correctamente desde la primera vez. Se deben utilizar técnicas especializadas.
¿Cómo se contagia? El Candida auris es capaz de extenderse entre pacientes o personal de salud por eso suele propagarse en hospitales.
“Es capaz de colonizar persistentemente a pacientes, o estar en manos del personal sanitario. Por lo tanto, es muy proclive a producir brotes hospitalarios”.
¿Quiénes son los más vulnerables al Candida auris? Las personas con más riesgo de la infección son las que tienen un sistema inmunológico comprometido por otro padecimiento. “Eso en un contexto como la pandemia del Covid-19 tiene la particularidad porque hay muchos pacientes que están necesitando llegar al hospital”, indicó Conde.
Es una variante que ha mostrado una fuerte resistencia a los medicamentos para tratar ese tipo de infecciones.

Factores de riesgo
El entrevistado descartó que acudir al hospital signifique infectarse, pero teme que la rotación habitual en un hospital pueda ocasionar un brote. Reiteró que el hongo es persistente al medio ambiente y suele permanecer en superficies o en las personas.
El factor de riesgo, indicó, es que el hongo C. auris entré a la sangre y produzca una infección. En ese sentido los más propensos son pacientes del área de intensivo, por Covid-19, o que hayan recibido asistencia de ventilación.
La enfermedad que provoca es severa por tener una alto nivel de invasión en el organismo.
¿Cómo prevenir infecciones por Candida auris? La recomendación son principalmente a los hospitales, según Conde. Deberán informar ante la sospecha de cualquier aislamiento de este tipo. También se deben mantener las buenas prácticas como el lavado de manos del personal y la desinfección de áreas con sustancias químicas, en caso atienden a un paciente por el C. auris. El amonio cuaternario no funciona, según el laboratorista, por lo que recomendó que se utilicen otras fórmulas para la tarea de limpieza.